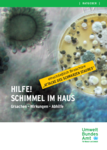

Fachinformationen
Fachberichte
In dieser ständig erweiterten Rubrik bieten wir Ihnen Fachinformationen an, die wir für nützlich und wissenswert halten.
Die Berichte liegen im PDF-Format für den Adobe Reader vor und sind dadurch auch hervorragend zum Ausdrucken geeignet!
Spezielle Fachberichte zum Thema Schimmel an und in der Orgel
Die Schimmelproblematik ist neben dem vor einigen Jahrzehnten verstärkt aufgetretenen Holzwurmbefall ein Phänomen, das seit über 10 Jahren (ca. ab 1995) zuerst verstärkt in Ostdeutschland und später auch in West- und Süddeutschland aufgetaucht ist.
Analog dazu taucht die Schimmelproblematik auch in sanierten Altbauwohnungen und an Vollwärmeschutzfassaden in Form von Algenbildung auf. Inzwischen haben sich viele Baubiologen mit diesem Phänomen beschäftig und unterschiedliche Gründe und Vorgehensweisen aufgezeigt.
Neu und besonders für den Orgelbau von Interesse sind die Ergebnisse des im Frühjahr 2018 von der Evang. Kirche Mitteldeutschlands beauftragten Forschungsgruppe zu diesem Thema speziell an Pfeifenorgeln. Neben vielen unterschiedlich zu bewertenden Einzelerkenntnissen, sind für den Orgelbauer in unseren Augen folgende Aussagen daraus zusätzlich zu anderen Erfahrungen interessant:
1. Beim normalen Benutzen einer schwach schimmelbefallenen Orgel droht dem Organist und dem Kirchenbesucher nicht sofort eine verstärkte Gesundheitsgefahr, weil bei den meisten Befällen die Pilzgattung Aspergillus (Gießkannenpilz) nachgewiesen wurde und dieser nicht gesundheitsgefährdend ist. Zur Abklärung eines großflächigen Schimmelbefalls muß allerdings zeitnah eine Pilzbestimmung zur Sicherheit aller Beteiligten vor gesundheitsgefährdenden Pilzen durchgeführt werden. Weiter sollten gesundheitlich angeschlagene Personen sich nicht unnötig den Pilzsporen aussetzen, um Gesundheitsprobleme nicht noch zu verstärken. Für den Orgelbauer selbst ist es auf jeden Fall sinnvoll, sich bei Arbeiten an der Orgel mit Staubmasken der Filterklasse P2 oder besser P3, Nitril-Einweghandschuhe und Einmal-Arbeitskleiderung zu schützen und wenn nötig nur Staubsauger mit Feinstaubfiltern einzusetzen. Besonders die Einmal-Arbeitskleidung und die Feinstaubfilter verhindern das unbeabsichtigte Weitertragen von Sporen an andere Orte.
2. Die seit 1995 in Deutschland verbesserte Atemluftqualität mit deutlicher Verringerung von Schwefeldioxid schafft bessere Wachstumsbedingungen für Schimmel. Verstärkter Feuchteniederschlag durch Temperaturschwankungen und nasse Sommer und milde Winter, begünstigt die Wachstumsgrundlage, die sich auch verzögert über durchfeuchtete Innenwände der Kirchenräume bemerkbar machen kann. Das sind 2 wesentliche Ursachen, die je nach örtlicher Situation sich mehr oder weniger auswirken können.
3. Bei vorhandenem Schimmel ist die Desinfektion der Orgelteile die erste Wahl. Da eine Desinfektion nur vorhandenen Schimmel beseitigen kann und damit keine Langzeitwirkung möglich ist, muß zur möglichst langen Verhinderung eines erneuten Schimmelbefalls zumindest eine zu hohe Luftfeuchtigkeit im Raum und in der Orgel vermieden werden. Je nach örtlicher Situation ist das durch kontrolliertes Lüften oder weiterführende Maßnahmen möglich und muß zeitnah angestrebt werden.
4. Als weitere Verhinderungsstrategie ist die Sauberhaltung des Instruments zu nennen. Größere Staubablagerungen, die auch gleichzeitig optimaler Nährboden für den Schimmel sind, müssen zeitnah entfernt werden.
Als Hintergrundinformationen empfehlen wir Ihnen die nachfolgend aufgelisteten Fachberichte zu diesem Thema.
Freundliche Grüße von OBM Johannes Weiblen

Hilfreiche Links

Bericht in der BG ETEM-Mitgliederzeitung 06-2016

Schimmel an Pfeifenorgeln OSV B. Goethe Wissenstand 2014

Vortrag Schimmelpilze von Dr. Ulrich Schmelz

Baudenkmäler und Publikumsverkehr

Kirchenheizungen mit Feuchtevorrangschaltung

Pilzbefall im Orgelbau

Schimmelbefall von Innenräumen und Gegenmaßnahmen
Info bzgl. Schimmel vom Bundesumweltamt

Heizen und Lüften von Wohnrämen

Lichtfarbe von Leuchtstoffröhren

Fachinfo Bleiweiß an Metallpfeifen


